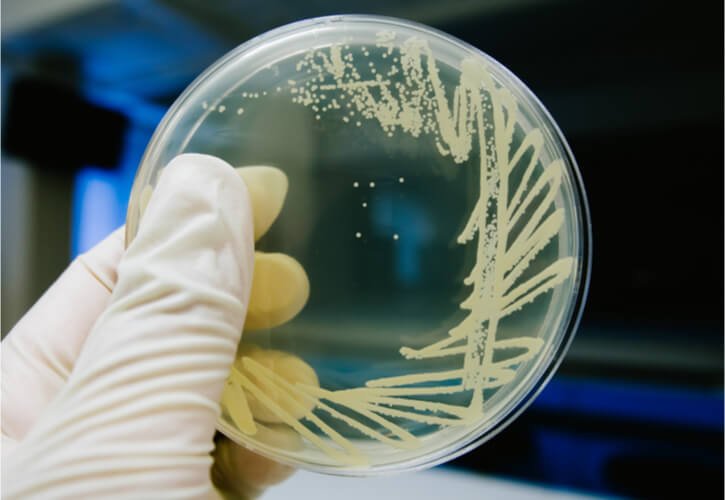

Prazis Healthcare
Prazis Healthcare Private Limited is a pharmaceutical company incorporated in the 2021, headquartered at Chennai. We are pioneers in bringing Commission E approved products in India. We challenge the limitations of conventional therapies. Some of the current treatment protocols (of modern medicine) for various indications have limitations and current research in medical science led to evolvement of newer therapeutic approaches.
Copyright © 2022 Prazis Healthcare Private Limited. All Rights Reserved.



